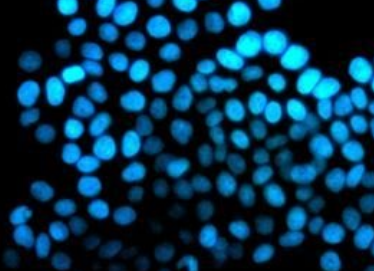

在生命科学与医药研发的前沿领域,微生物正逐渐成为药物发现的 “新宝藏”。其中,硫细菌以其独特的代谢能力和丰富的天然产物合成机制,成为药物开发的热点对象。尤其是富硫细菌环肽的生物合成研究,为新型药物的研发开辟了全新路径,有望...

尽管硫细菌在碳循环、生态修复等多领域展现出巨大的应用潜力,但从实验室研究迈向大规模产业化应用,仍面临诸多亟待攻克的难关。这些挑战不仅制约着硫细菌技术的推广,也为科研人员指明了未来的探索方向。

在人类迈向深空的宏伟征程中,资源短缺与极端环境始终是横亘在前的重大挑战。从月球的荒芜尘埃到火星的赤红荒漠,传统技术在开发星际资源时面临诸多局限。而硫细菌,这种地球上的极端环境生存专家,正凭借独特的代谢能力,为太空探索开辟...

在水产养殖领域,硫细菌正以其独特的生态调控能力,成为推动行业绿色转型的核心力量。从水质净化到病害防控,从营养循环到环境适应,硫细菌的应用贯穿养殖全流程,为水产养殖业带来新的变革。

在传统冶金行业面临高能耗、高污染困境的当下,一场由微生物主导的绿色革命正在悄然兴起。硫细菌,这群微观世界的 “冶金大师”,凭借独特的代谢能力,为金属提取开辟了全新路径,推动生物冶金技术从实验室走向工业化应用。

在全球能源转型的浪潮中,微生物燃料电池(MFC)作为一种将生物能转化为电能的前沿技术,正吸引着无数科研人员的目光。而硫细菌,凭借其独特的代谢特性,成为了微生物燃料电池领域极具潜力的 “能量引擎”,为可持续能源生产带来了新的曙...
在全球农业追求绿色可持续发展的当下,微生物技术正成为革新传统种植模式的关键力量。硫细菌凭借其独特的代谢功能,在土壤修复、植物营养供给和病虫害防治等方面展现出巨大潜力,为现代农业的绿色转型提供了新的解决方案。

在地球上最严酷的环境中,隐藏着一群生命力顽强的 “微生物战士”—— 硫细菌。它们广泛分布于高温、低温、强酸、强碱、高盐等极端环境,以独特的生存策略在这些 “生命禁区” 中繁衍生息,堪称极端环境中的生存大师。